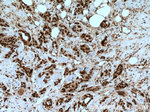
RAD21 Antibody in Immunohistochemistry (Paraffin) (IHC (P))

Search
Proteintech
RAD21 Polyclonal Antibody
{{$productOrderCtrl.translations['antibody.pdp.commerceCard.promotion.promotions']}}
{{$productOrderCtrl.translations['antibody.pdp.commerceCard.promotion.viewpromo']}}
{{$productOrderCtrl.translations['antibody.pdp.commerceCard.promotion.promocode']}}: {{promo.promoCode}} {{promo.promoTitle}} {{promo.promoDescription}}. {{$productOrderCtrl.translations['antibody.pdp.commerceCard.promotion.learnmore']}}
产品信息
27071-1-AP
种属反应
宿主/亚型
分类
类型
抗原
偶联物
形式
浓度
规格
纯化类型
保存液
内含物
保存条件
运输条件
靶标信息
This gene encodes a nuclear protein that regulates transcriptional elongation and pre-mRNA splicing. The encoded protein interacts with the hyperphosphorylated C-terminal domain of RNA polymerase II via multiple FF domains, and with the pre-mRNA splicing factor SF1 via a WW domain. Alternative splicing results in multiple transcripts variants encoding different isoforms.
仅用于科研。不用于诊断过程。未经明确授权不得转售。
生物信息学
蛋白别名: Double-strand-break repair protein rad21 homolog; FLJ25655; FLJ40596; h NXP-1; hHR21; HR21spA; KIAA0078; KIAA0078RAD21; kleisin; Nuclear matrix protein 1; NXP-1; protein involved in DNA double-strand break repair; RAD21 homolog; SCC1 homolog; sister chromatid cohesion 1; unnamed protein product
基因别名: CDLS4; hHR21; HR21; HRAD21; KIAA0078; MCD1; MGS; NXP1; RAD21; SCC1
UniProt ID: (Human) O60216
Entrez Gene ID: (Dog) 482021, (Human) 5885